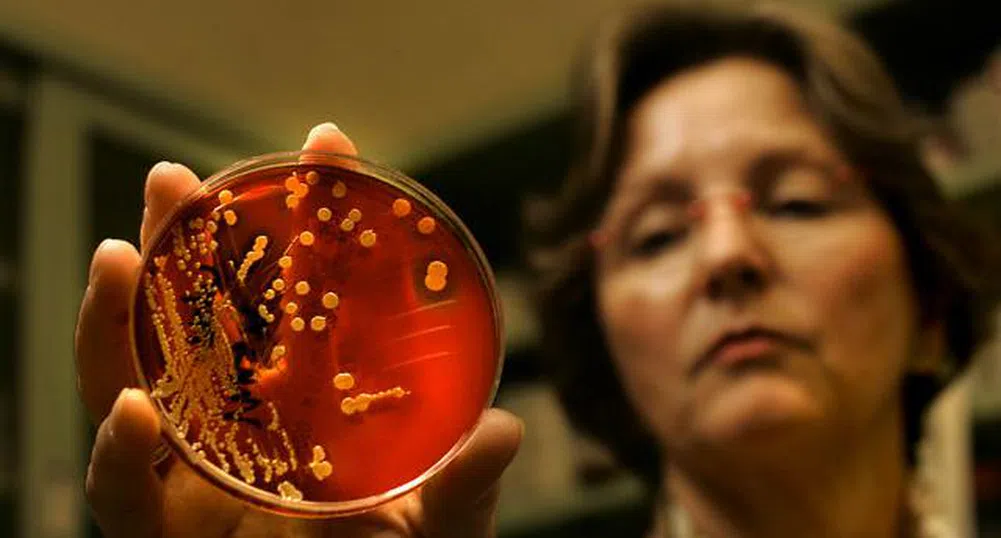
Примитивна бактерия произвежда гориво за ракети

Примитивна бактерия произвежда гориво за ракети
&format=webp)
В резултат на задълбочена изследователска работа екип от холандски учени доказва как една примитивна бактерия прави коктейл от протеини, който може да произведе вещество, използвано за гориво в ракетите.
Преди няколко години бактерията Коенения стутгартиенсис (Kuenenia stuttgartiensis) смая учените със способността си да превръща амония (NH 4) - замърсител, съдържащ се във водата, в газообразен азот, без да използва кислорода.
Възможно е този тип бактерии, наричани "annamox" да произвеждат от 30 до 50% от азота в земната атмосфера.
Особен интерес към тях проявяват океанографите, климатолозите и специалистите по обработка на отпадните води. Използват ги вече в пречиствателните станции.
Учени от университета Радбуд в Нимег, Холандия, обясняват как Kuenenia stuttgartiensis използва също амоний, за да произвежда хидразин (N2H4) - химично съединение, използвано като гориво в ракетите.
Не бе лесно, но успяхме да изолираме смесица от протеини, произвеждащи хидразин, обясняват холандските изследователи в научното си съобщение.
Американската космическа агенция НАСА също се заинтересувала как може да се направи гориво за ракети от азотни съединения, които се намират в големи количества, в урината например. За съжаление холандците са произвели малки количества, крайно недостатъчни да бъде изпратена ракета до Марс.
Хидразинът има приложение и в горивните батерии, разработени от японския автомобилостроител Дайхацу. Тази техника има предимството, че не използва редки и скъпи метали като платината.
Източник: БГНЕС
)
&format=webp)
&format=webp)
&format=webp)
&format=webp)
&format=webp)
&format=webp)
&format=webp)
,fit(1920:897)&format=webp)
,fit(140:94)&format=webp)
,fit(140:94)&format=webp)
,fit(140:94)&format=webp)
,fit(1920:897)&format=webp)
,fit(140:94)&format=webp)